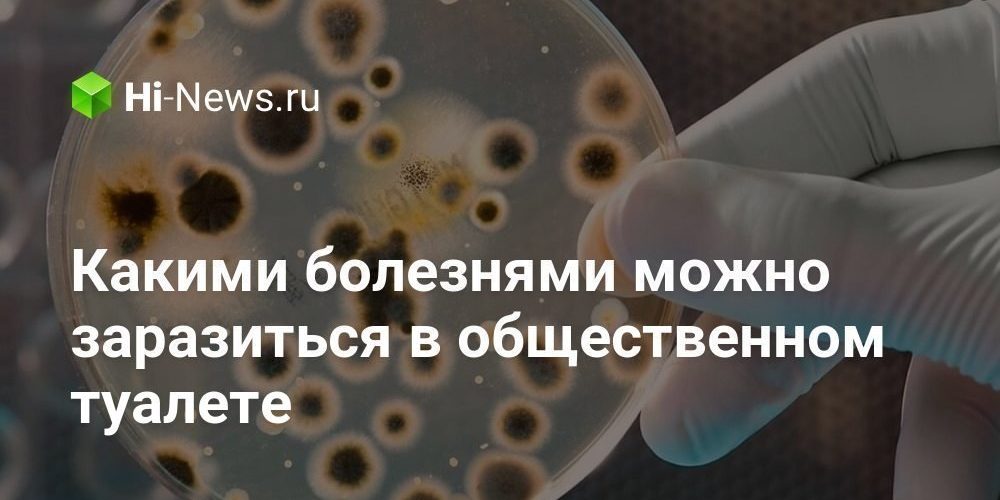

В общественных туалетах очень грязно и можно заразиться опасными вирусами
По отзывам некоторых путешественников, самые лучшие общественные туалеты находятся в ОАЭ. Там очень развита культура шопинга, поэтому люди могут проводить в магазинах чуть ли не целый день. За это время им явно хочется «по-маленькому», поэтому владельцы таких заведений очень заботятся о комфортности и чистоте кабин в уборных — часто там играет музыка, есть вай-фай и так далее. Но в Азии, Европе, России и других странах дела с этим обстоят гораздо хуже. Общественные туалеты чистятся не так часто, как хотелось бы, и там очень грязно. Многие люди боятся туда заходить из-за риска заразиться каким-либо заболеванием и не без оснований — в туалетах огромное количество болезнетворных бактерий. Давайте узнаем, чем можно там заразиться и что делать, чтобы этого не произошло?
Содержание статьи
Болезни в общественных туалетах
В основном туалеты полны фекальными бактериями. Это вполне логично, учитывая, с какой целью люди туда ходят. Какие именно микробы могут проникнуть в организм при контакте со стульчаком, стенами и дверной ручкой, узнать невозможно. Скорее всего, ими будут представители следующих видов.
Общественные туалеты в хороших местах регулярно очищаются, но там все равно много бактерий
Кишечная палочка — возбудитель инфекций
Кишечная палочка Escherichia coli обитает в нижней части кишечника, и большинство ее штаммов безвредны. Проблемы начинаются при попадании в организм патогенных штаммов, особенно если они проникают в другие полости тела человека. Например, если кишечная палочка оказывается в брюшной полости, возникает перитонит — тяжелое заболевание, при котором напрягаются мышцы брюшной стенки, возникает боль в животе и другие симптомы.
Кишечная палочка Escherichia coli
Чаще всего кишечная палочка вызывает следующие болезни:
- инфекция пищеварительного тракта (гастроэнтерит);
- инфекции мочевыводящих путей;
- инфекция предстательной железы (простатит);
- пневмония.
Возможно, вы были удивлены тому, насколько много болезней может возникнуть из-за кишечной палочки. Такова суровая правда, иногда эти палочковидные бактерии очень опасны. Диарея, тошнота и рвота — это минимум, что они могут натворить.
Вам будет интересно: Почему кухонная губка — самый грязный предмет в вашем доме
Сальмонелла — возбудитель сальмонеллеза
Существуют разные виды сальмонелл, и все они очень опасны. Проникая в организм, они могут вызвать сальмонеллез, при котором у человека ухудшается самочувствие, повышается температура, возникает рвота и частые позывы в туалет. В некоторых случаях эти бактерии способны спровоцировать развитие менингита, остеомиелита и сальмонеллезной пневмонии.
Сальмонеллы являются возбудителями целого ряда опасных болезней
Сальмонеллы вида Salmonella typhi могут стать причиной возникновения брюшного тифа. При этом заболевании возникает лихорадка, появляются высыпания на коже и другие тяжелые симптомы. Если верить статистике, в 2000 году брюшным тифом переболели 21,6 миллионов человек, причем 1% случаев закончился смертью.
Недавно сальмонеллы научились прятаться в складках растений и водой их уже не смыть. Вот подробности.
Стафилококки — причина воспалений
Существует несколько видов бактерий стафилококков, и большинство из них крайне опасны для людей. В качестве примера, золотистый стафилококк (Staphylococcus aureus) запускает гнойные воспалительные процессы в организме: могут возникнуть фурункулы и другие образования. Также существует эпидермальный стафилококк (Staphylococcus epidermidis), который активен в слизистых оболочках и вызывает конъюнктивит, гнойные инфекции ран и другие проблемы.
Золотистый стафилококк (Staphylococcus aureus)
Против стафилококка можно использовать бактерии, которые живут на шерсти кошек. Вот результаты исследования.
Венерические заболевания в туалете
После перечисления всех этих болезней становится не по себе. Но еще больше люди бояться того, что в туалете можно подцепить болезни, передающиеся половым путем. Речь идет о ВИЧ, герпесе, гонорее и других страшных заболеваниях. На самом деле, риск заражения ими в общественном туалете минимален — возбудители выживают на открытом воздухе не более 10 секунд. Так что пострадать от них можно только при прямом, незащищенном контакте с носителем.
Подцепить передающуюся половым путем болезнь через унитаз почти невозможно
Самые грязные места в туалете
Большинство людей считают, что самое грязное место в общественном туалете — это унитаз. Но это не всегда так, потому что в приличных местах его регулярно очищают при помощи сильнодействующих средств. Чаще всего бактерии размножаются на кнопке смыва, на ручке двери и полу — его реже моют.
Пол туалета кишит опасными бактериями
Как себя вести в общественном туалете?
Большинство людей первым делом кидают на стульчак несколько слоев туалетной бумаги. Однако, для болезнетворных бактерий это не такой уж и сильный барьер — они вполне могут его обойти и проникнуть в организм. Во многих случаях на унитазе нет опасных микробов, и туалетная бумага просто помогает людям немного побороть неприязнь.
Чтобы не заразиться болезнями в туалете, достаточно придерживаться следующих правил:
- никогда не ставьте сумку на пол, потому что там больше всего бактерий;
- не касайтесь стенок кабины, на них тоже полно грязи;
- на кнопку смыва лучше нажимать через кусок туалетной бумаги;
- после посещения важно помыть руки с мылом (вот как правильно это делать).
Главное правило — регулярно мыть руки
Если вы все еще этого не сделали, подпишитесь на наш канале в телеграме. Еще чуть-чуть, и нас будет 8 000!
Вот еще одно важное правило — перед смывом обязательно закрывайте крышку! Если смыть унитаз просто так, опасные бактерии могут проникнуть в организм еще проще и в большом количестве. Вот объяснение.